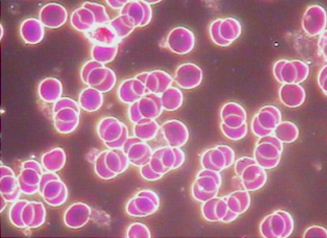

Discover the Future of Wellness: Non-Invasive INJECTION-FREE Cellular Renewal
Grow Your Practice with StemRenew: Cutting-Edge, Injection-Free Biophoton Technology
Groundbreaking Results: Preliminary data shows that StemRenew Technology can increase natural production of new cells by 300+% in just two weeks. In a pilot study, our volunteers experienced this remarkable increase of self-grown new cells, enhancing their overall health and vitality.
Science-Backed Data: Multiple IRB-approved clinical trials include The Impact of Biophoton Therapy on Self-Grown Stem Cells ClinicalTrials.gov:NCT06855459
Business Growth: Recoup your initial investment in as little as one month!
works by harnessing the power of biophoton energy to stimulate the body’s ability to generate new cells, supporting natural repair and regeneration. This simple process provides a natural, non-invasive way to restore youthful energy, enhance recovery, and slow down the aging process.

Before: The body’s natural new cell production at baseline. This represents the body’s natural average cell production level without any intervention.
After: After just 7-14 days of biophoton energy exposure, new cell activity skyrockets 300+%—a remarkable impact on the body’s natural healing potential. This is an unparalleled result that shows how the body can be naturally rejuvenated without invasive treatments.
COMPARE BLOOD FLUIDITY

Before Biophoton Therapy
Red blood cells show significant aggregation (rouleaux formation), appearing stacked and clumped together, which impairs microcirculation
and oxygen transport. The surrounding plasma environment contains visible white crystalline or amorphous particles, suggesting potential protein debris, oxidative stress byproducts, or
poor metabolic clearance - all indicators of a biologically stressed
system.
5 Days of Biophoton Therapy
Red blood cells appear round, evenly spaced, and show uniform staining, indicating restored membrane flexibility and reduced aggregation. The intercellular environment is notably clearer, with fewer visible crystalline deposits. This suggests reduced oxidative stress, improved metabolic function, and a shift toward homeostasis in
the blood plasma matrix.

12 Days of Biophoton Therapy
Red blood cells maintain optimal morphology and free-flowing distribution, supporting efficient microcirculation and oxygen delivery. The plasma environment appears clean and transparent, with minimal to no visible crystalline artifacts. This reflects enhanced detoxification, improved cellular communication, and restoration of biochemical balance, which collectively support higher systemic vitality and regenerative
capacity.


COMPARE TREATMENT OPTIONS

"I feel like a huge weight has been lifted off of me. My mood is better, my energy is up, and I feel at peace. It’s truly amazing how much my well-being has improved!"
—Jennifer L.
"Great from beginning to end. The hours flew by and I felt so cared for the whole time. Thank you for your wonderful care. Be still, pay attention to your body and you will feel the changes taking place."
—Sharon G.
About Us
Our Mission
Blog
Whitepapers
info@stemrenewclinical.com
(800) 123-4567
©2025 StemRenew. All Rights Reserved. Privacy Policy